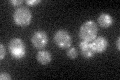
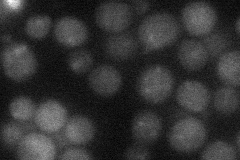
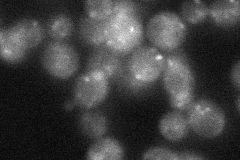
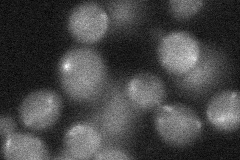
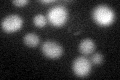
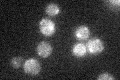

View description
One of 10 subunits of the transport protein particle (TRAPP) complex of the cis-Golgi which mediates vesicle docking and fusion; mutations in the human homolog cause the spondyloepiphyseal dysplasia tarda (SEDL) disorder
Localization:
Intensity:
Fold change:
Significance:
-
C’ GFP library in SD
punctate22.64 -
N' NOP1pr-GFP in SD

cytosol,punctate66.086 -
N' TEF2pr-mCherry in SD
cytosol,punctate24.8095 -
N' NATIVEpr-GFP in SD
punctate23.4055 -
N' TEF2pr-VC and Cyto-VN in SD
below threshold28.266 -
C’ GFP library in SD+DTT
punctate22.10.97No -
C’ GFP library in SD+H2O2

cytosol22.320.98No -
C’ GFP library in Starvation Media
punctate22.560.99No -
C’ GFP library on the background of Pup2-DaMP

punctate -
C’ GFP library on the background of CCT mutant

punctate19.47610.860066No
